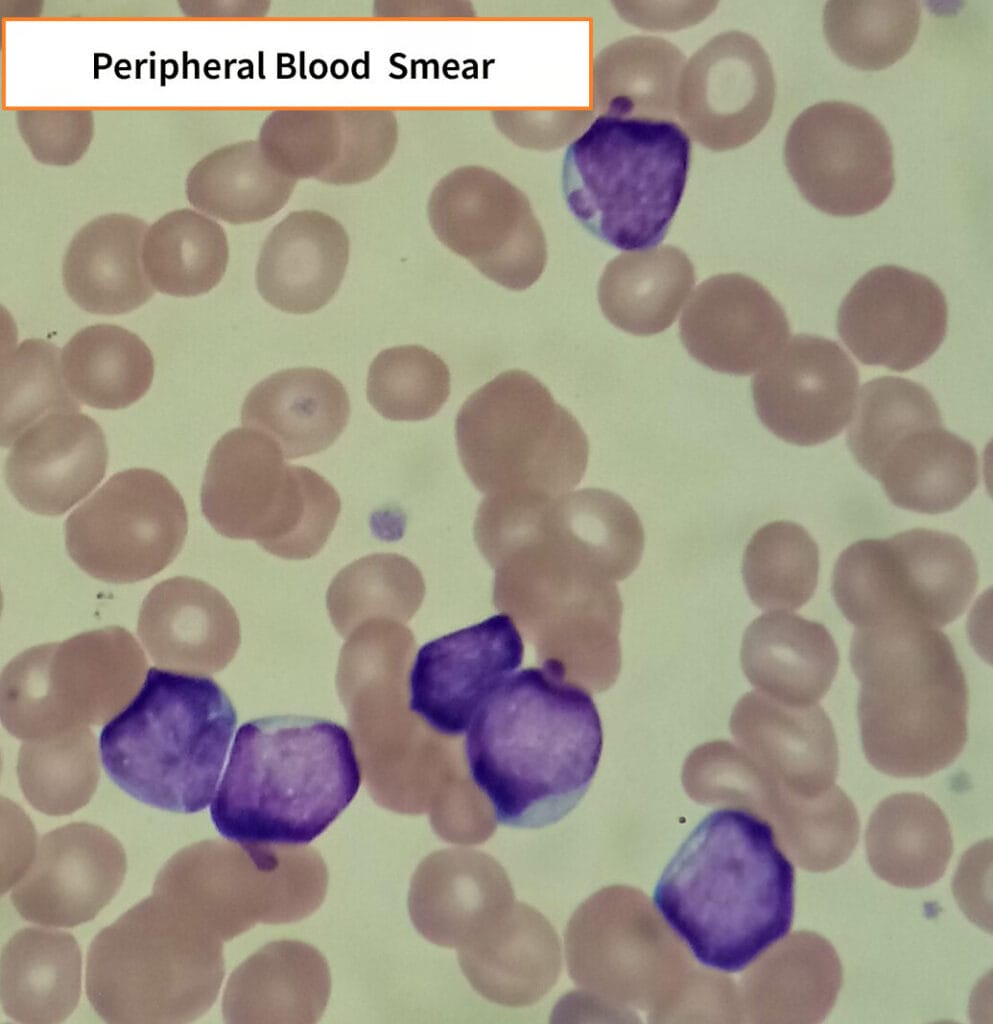

Table of Contents
급성 림프구성 백혈병 (Acute Lymphoblastic Leukemia, ALL)
Acute Lymphoblastic Leukemia, ALL: 림프모세포의 비정상적인 증식
급성 림프구성 백혈병(Acute Lymphoblastic Leukemia, ALL)은 성숙하지 않은 림프구, 즉 림프모세포(lymphoblast)가 비정상적으로 증식하면서 골수를 침범하고, 말초혈액 및 전신 장기로 퍼지는 질환입니다. 소아에서 가장 흔한 백혈병이며, 성인에서도 발생할 수 있습니다.

비정상 림프구 전구세포가 골수에서 증식하여 빈혈, 감염, 출혈 및 림프절 비대 등을 유발합니다.
| 급성 림프구성 백혈병 (Acute Lymphoblastic Leukemia, ALL) |
| ✅ 림프모세포가 골수에서 과도하게 증식하여 정상 조혈기능을 억제하는 급성 혈액암입니다. |
| ✅ 진단 기준 |
| 골수 또는 말초혈액에서 림프모세포(lymphoblast)가 전체 핵세포의 20% 이상일 때 ALL로 진단합니다. WHO 분류를 따르며, 면역표현형, 유전자 이상에 따라 분류와 예후가 달라집니다. |
| 급성 림프구성 백혈병 (Acute Lymphoblastic Leukemia, ALL) |
| 🟦 골수에서 미성숙 림프구가 급속히 증식하면서 정상 조혈기능이 억제되고, 전신에 침윤됩니다. |
AML과의 비교
AML vs ALL
: 보시면 대충 느낌이 오겠지만 Lymphoblast 가 좀 더 꽉 차있고 (?) 진합니다.

✅ Myeloblast (골수모세포)
- Cytoplasm이 적당히 있음 (Moderate amount)
- Chromatin이 약간 가늘게 분산되어 있음 (Fine lacecy chromatin)
- Nucleoli가 뚜렷함. 2~5개까지 관찰됨 (Prominent Nucleoli)
- Auer Rod를 포함할 수도 있다!

✅ Lymphoblast (림프모세포)
- Cytoplasm이 거의 없다 (Scant amount)
- Chromatin이 조밀하다, 성숙한 형태 (Dense chromatin)
- Nucleoli가 뚜렷하지 않음 . (Indistinct Nucleoli)
- Auer Rod가 있을 수 없다!
원인
정확한 원인은 밝혀지지 않았지만, 유전적 이상과 환경적 요인이 관여합니다.
| 주요 원인 |
| 🔴 다운 증후군(Down syndrome) |
| 선천성 염색체 이상으로 ALL 발생 위험이 증가합니다. |
| 🔴 방사선 노출 |
| 태아기 또는 어린 시절의 방사선 노출은 위험을 높일 수 있습니다. |
| 🔴 특정 유전자 이상 |
| BCR-ABL (Philadelphia 염색체), TEL-AML1 등은 예후 및 치료 반응에 영향을 줍니다. |
| 🔴 치료 후 백혈병(Therapy-related ALL) |
| 항암제나 방사선 치료 후 발생하는 이차성 백혈병입니다. |
임상양상
골수 기능 저하 증상과 림프조직 침윤 증상이 동시에 나타납니다.
피로, 발열, 잦은 감염과 함께 림프절 종대, 간비비대, 뼈 통증 등을 호소합니다.
| 증상 및 징후 |
| 🟨 빈혈 증상(창백, 피로, 호흡곤란) |
| 적혈구 생산 감소로 빈혈이 생깁니다. |
| 🟨 출혈 경향 |
| 혈소판 감소로 멍, 코피, 잇몸출혈 등이 발생합니다. |
| 🟨 감염, 발열 |
| 호중구 감소로 감염에 취약해지고, 발열이 흔하게 나타납니다. |
| 🟨 림프절 비대, 간비비대 |
| 림프조직에 백혈병 세포가 침윤하여 종대가 발생합니다. |
| 🟨 중추신경계 침범 |
| 두통, 구토, 복시 등이 나타날 수 있으며, 소아에서 더 흔합니다. |
진단
골수검사 및 유전자 검사로 진단하며, 중추신경계 침범 확인도 필요합니다.
| 진단 방법 |
| 🔵 말초혈액 도말(PB smear) |
| 모세포(blast)가 보이며, 림프구 계통 특성 확인이 필요합니다. |
| 🔵 골수검사(Bone marrow study) |
| 골수에서 림프모세포가 전체 세포의 ≥20% 이상이면 ALL로 진단합니다. |
| 🔵 면역표현형검사(Flow cytometry) |
| CD10, CD19(B세포), CD3, CD7(T세포) 등 림프구 계통 마커 확인 |
| 🔵 세포유전학 및 분자유전학 |
| Philadelphia chromosome(BCR-ABL) 여부 확인은 치료 전략에 중요합니다. |
| 🔵 뇌척수액 검사(CSF tap) |
| 중추신경계 침범 여부를 확인하고, 치료 방침 결정에 활용합니다. |

치료
치료의 핵심 목표는 완전관해를 달성하고, 재발을 방지하는 것입니다.
ALL 치료는 유도요법 → 공고요법 → 유지요법 → 중추신경계 예방요법 순으로 진행됩니다. Philadelphia 염색체 양성(Ph+) ALL은 티로신 키나아제 억제제를 병용합니다.
유도요법
첫 단계로, 백혈병세포를 감소시켜 완전관해를 유도합니다.
| 항암 요법 |
| 🔷 Vincristine, Prednisolone, Daunorubicin, L-asparaginase |
| 여러 항암제 병용으로 모세포를 효과적으로 제거합니다. |
| 💊 Vincristine(빈크리스틴) |
| 미세소관 형성을 억제하여 세포분열을 차단합니다. |
| 💊 Prednisolone(프레드니솔론) |
| 림프세포에 대한 독성을 지닌 스테로이드입니다. |
공고요법 및 유지요법
공고요법은 관해 후 남아있는 세포 제거 목적, 유지요법은 장기적 재발 억제를 목표로 합니다.
| 공고 및 유지요법 |
| 🔷 6-Mercaptopurine, Methotrexate 등 |
| 경구 항암제 복용으로 수개월~수년간 유지요법을 지속합니다. |
중추신경계 예방요법
뇌척수액 내 백혈병 세포 침윤 방지를 위한 예방적 치료입니다.
| 척수강 내 항암제 투여 |
| 🔷 Methotrexate, Cytarabine을 뇌척수강 내로 직접 주입 |
| 소아에서 반드시 시행하며, 재발률을 낮추는 데 매우 중요합니다. |
예후
소아의 예후는 좋은 편이나, 성인에서는 예후가 나쁠 수 있습니다.
| 예후 |
| 🟧 소아 ALL |
| 표준 치료에 대한 반응이 좋고, 장기 생존율이 80~90%에 달합니다. |
| 🟧 성인 ALL |
| 재발률이 높고, 이식 요법을 동반해야 장기 생존이 가능합니다. |
| 🟧 Philadelphia chromosome 양성(Ph+) |
| 예후가 불량하며, TKI 병용 및 조혈모세포이식이 필요합니다. |


